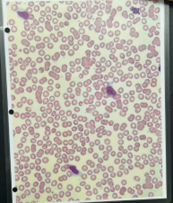

1/26
chapter 5
Name | Mastery | Learn | Test | Matching | Spaced | Call with Kai |
|---|
No analytics yet
Send a link to your students to track their progress

adipose tissue

areolar CT
blood

bone tissue

cardiac muscle

dense irregular CT

dense regular CT

elastic cartilage

fibrocartilage

hyaline cartilage (microscope)

hyaline cartilage

keratinized stratified squamous

nervous tissue

pseudostratified ciliated columnar

reticular CT

simple columnar

simple cuboidal ET

simple cuboidal ET

simple squamous - lung

skeletal muscle

smooth muscle

Urothelium/Transitional Epithelium

interphase

prophase (pile of fuzz)

metaphase (meet in the middle)

anaphase (pulled apart)

telophase (pinches in)